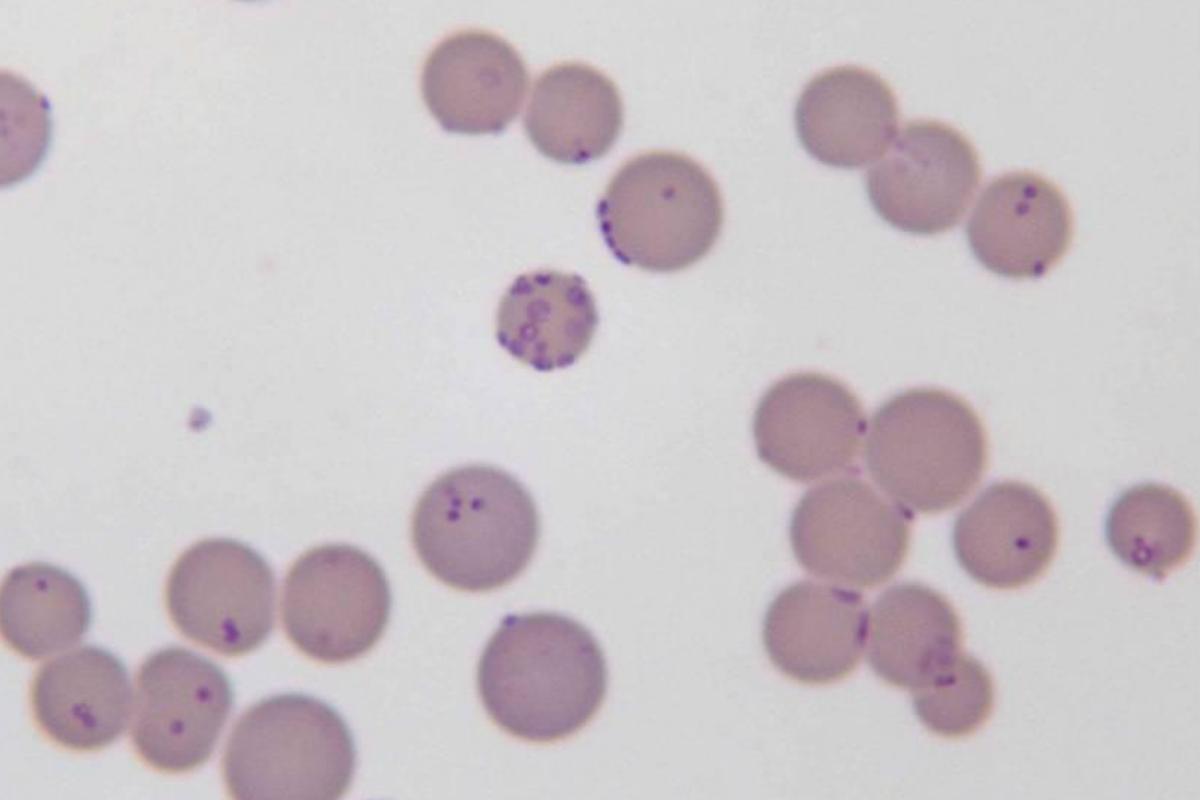

Micoplasmosis en gatos - Síntomas y tratamiento



Ver fichas de Gatos
La micoplasmosis felina o anemia infecciosa felina es una enfermedad causada por la bacteria parasitaria Mycoplasma haemofelis que suele pasar desapercibida en los individuos que la padecen, no obstante, en los casos más graves se manifiesta como una anemia grave en los gatos, que puede llegar a causar la muerte del individuo.
En este artículo de ExpertoAnimal te explicaremos todo lo que necesitas saber sobre la micoplasmosis en gatos, síntomas y tratamiento de la enfermedad. No obstante, si sospechas que tu gato padece anemia infecciosa felina será fundamental visitar a tu veterinario para poder realizar un diagnóstico diferencial.
- Mycolpasmosis en gatos
- Causas de la micoplasmosis en gatos
- Transmisión de la micoplasmosis felina
- Síntomas de mycoplasma en gatos
- Diagnóstico de la micoplasmosis en gatos
- Tratamiento para el mycoplasma haemofelis
- ¿La infección por mycoplasma haemofelis tiene cura?
- Prevención de la micoplasmosis felina
Mycolpasmosis en gatos
La micoplasmosis felina (Mycoplasma felis), también conocida como anemia infecciosa felina, es una enfermedad que puede transmitirse a través de la picadura de ectoparásitos infectados, es decir, parásitos que se encuentran en la piel de los animales. Los vectores más comunes son pulgas y garrapatas, por este motivo es tan importante la prevención mediante la desparasitación regular del felino.
Sin embargo, también puede aparecer provocada por una transmisión iatrogénica, como consecuencia de un acto médico, a través de la transfusión de sangre contaminada.
Descubre aquí Los mejores productos para desparasitar gatos.

Causas de la micoplasmosis en gatos
Una vez entra en el torrente sanguíneo a través de la picadura de pulgas y garrapatas infectadas, el Mycoplasma haemofelis se adhiere parcialmente a la superficie de los glóbulos rojos causando su hemólisis, es decir, destruyéndolos, y provocando así la aparición de anemia en el gato.
Estudios afirman que fueron identificadas dos subespecies distintas de Haemobartonella felis: una forma grande y relativamente patógena y más peligrosa, que causa anemia severa, y otra más pequeña y menos virulenta.
Es importante señalar que, incluso habiendo estado en contacto con la bacteria, existen animales que no desarrollan la enfermedad y que además son asintomáticos: no muestran síntomas de enfermedad. En este caso hablamos de animales portadores que no manifiestan la enfermedad pero pueden transmitirla.
Esta patología también puede mantenerse latente y manifestarse cuando el gato está débil, estresado o inmunodeprimido, por ejemplo en animales que padecen el virus de la inmunodeficiencia felina o la peritonitis infecciosa felina, ya que esta bacteria aprovecha la debilidad del animal para reproducirse.
No dudes en consultar más información sobre la Anemia en gatos: síntomas y tratamiento y la Peritonitis infecciosa felina (PIF): sus síntomas y tratamiento en estos otros dos artículos de ExpertoAnimal.
Transmisión de la micoplasmosis felina
La transmisión de la micoplasmosis en gatos se produce por contacto o a través de la saliva. No obstante, las interacciones que implican agresión, como peleas, mordeduras o arañazos pueden causar finalmente la transmisión, ya que en estos casos los animales pueden estar expuestos a la sangre de un animal infectado. Cualquier felino puede padecer esta patología, sin importar la edad, la raza o el sexo.
Según varios estudios, los machos parecen estar más predispuestos a padecerla que las hembras, debido principalmente a las peleas callejeras, especialmente durante las épocas de primavera y verano, cuando el número de pulgas y garrapatas se dispara, aumentando así el riesgo de infestación.
Existen dudas sobre si el micoplasma en gatos se contagia a humanos. La respuesta es que es una enfermedad que se transmite entre animales, por lo que los humanos podemos vernos afectados por ella debido a nuestra estrecha relación con estos.
¿Cómo eliminar pulgas en gatos? Descubre la respuesta en este otro post.

Síntomas de mycoplasma en gatos
Aunque el mycoplasma en gatos puede presentar signos clínicos evidentes, existen otros casos en los que no se muestran signos clínicos, ya que depende de la patogenicidad del agente, de la capacidad del mismo de causar la enfermedad, el estado de salud del animal y la cantidad de agente inoculada durante las peleas o la picadura de los vectores.
Así pues, la infección puede ser asintomática, como en una anemia leve, o pueden aparecer signos clínicos muy evidentes. A continuación te mostramos los síntomas de la micoplasmosis en gatos más evidentes:
- Anemia.
- Depresión: te sugerimos este post para saber si Mi gato está deprimido: causas, síntomas y tratamiento.
- Debilidad.
- Agrandamiento del bazo.
- Anorexia: consulta más información sobre la Anorexia en gatos: causas, síntomas y tratamiento en este otro artículo de ExpertoAnimal.
- Pérdida de peso.
- Deshidratación: si quieres descubrir Cómo saber si un gato está deshidratado, lee este post que te sugerimos.
- Mucosas blancas.
- Mucosas amarillas.
- Fiebre: averigua más sobre la Fiebre en gatos: las causas, síntomas y cómo bajarla.
Diagnóstico de la micoplasmosis en gatos
Para identificar y visualizar el parásito, el veterinario suele llevar a cabo las siguientes pruebas para el diagnóstico:
- Frotis de sangre
- Reacción en cadena de la polimerasa (PCR)
No obstante, puede ocurrir que la técnica molecular PCR no esté disponible en nuestro país o clínica y que el frotis de sangre sea un poco sensible, provocando que la presencia de Mycoplasma haemofelis en el gato sea difícil de reconocer. Así mismo, los pacientes que den resultados positivos en PCR pueden ser portadores de la enfermedad pero no manifestarla de forma activa, en cuyo caso no será necesario tratarla.
El veterinario puede sugerirnos además un conteo sanguíneo completo o hemograma (CBC) para visualizar de forma detallada el estado general del animal y ayudar así a ofrecer un diagnóstico definitivo.
El diagnóstico diferencial de esta patología suele ser muy complicado, por lo que se deben considerar todos los aspectos posibles del animal, incluyendo el historial clínico, los síntomas clínicos, diversos análisis y los exámenes completos. Además, no deben tenerse en cuenta únicamente en gatos que presenten anemia, sino en todos aquellos que tienen un historial recurrente de infestación parasitaria.

Tratamiento para el mycoplasma haemofelis
De forma general, el tratamiento indicado ante un cuadro de micoplasmosis felina consiste en la administración de antibióticos en el gato, corticoides, fluidoterapia y, en algunos casos, una transfusión. No olvides que el tratamiento debe estar siempre prescrito por un veterinario, quien ajustará las dosis según el peso, las necesidades del individuo, el historial clínico del paciente y los resultados de las pruebas.
Un tratamiento adecuado y personalizado, así como los cuidados de soporte, son fundamentales para asegurar el éxito del tratamiento y la calidad de vida de nuestro felino. Así mismo, un diagnóstico temprano es esencial para un tratamiento exitoso.
¿Puedo dar antibióticos a mi gato? Averigua la respuesta en este artículo de ExpertoAnimal que te sugerimos.
¿La infección por mycoplasma haemofelis tiene cura?
La anemia infecciosa felina sí tiene cura, además, un animal recuperado ya no presentará síntoma alguno de enfermedad. Sin embargo, los gatos que han superado esta patología se convierten en portadores asintomáticos por tiempo indefinido, ya sea durante algunos meses o hasta la muerte del animal.
Prevención de la micoplasmosis felina
La principal medida de protección contra la micoplasmosis es evitar la presencia de ectoparásitos a través de la desparasitación del gato. Si bien la primavera y el verano son las épocas de más riesgo, debido al cambio climático esta rutina debe estar presente durante todo el año. Además, debemos cumplir con el calendario de vacunación del gato para evitar que ciertas dolencias inmunomediadas desencadenen la infección del mycoplasma haemofelis.
También se aconseja la castración del gato, un procedimiento quirúrgico en el que se extraen los órganos sexuales. Ello favorece que se reduzcan las conductas relacionadas con la agresividad, el escapismo y el marcaje, comportamientos que provocan la predisposición a padecer una infestación parasitaria y la participación en peleas.
Este artículo es meramente informativo, en ExpertoAnimal.com no tenemos facultad para recetar tratamientos veterinarios ni realizar ningún tipo de diagnóstico. Te invitamos a que lleves a tu mascota al veterinario en el caso de que presente cualquier tipo de condición o malestar.
Si deseas leer más artículos parecidos a Micoplasmosis en gatos - Síntomas y tratamiento, te recomendamos que entres en nuestra categoría de Enfermedades parasitarias.
- Coelho, P. C. M. S. Angrimani, D. S. R. Marques, E. S. (2011) Micoplasmose Em Felinos Doméstico: Revisão De Literatura. Revista científica eletrônica de medicina veterinária – ISSN: 1679-7353, 16, p.1-1
- Kewish, K. E. Appleyard, G.D. Myers, S.L. Kidney, B.A.. Jackson, M.L. (2004) Mycoplasma haemofelis and Mycoplasma haemominutum detection by polymerase chain reaction in cats From Saskatchewan and Alberta. Can Vet J 45(9), p.749–75
- Martinez, M.S. Charas dos Santos, I.F. Kolber, M. (2016) Análise Hematológica Em Gatos Domésticos (Felis Silvestris Catus) Diagnosticados Com Micoplasmose Em Osasco, São Paulo – Brasil. Revista Lusófona de Ciência e Medicina Veterinária. 8, p.1-9
- Walker Vergara, R. Morera Galleguillos, F., Gómez Jaramillo, M. Pereira Almosny, NR. Arauna Martínez, P. Grob Behne, P. Acosta-Jamett, G. Müller, A. (2016) Prevalence, Risk Factor Analysis, And Hematological Findings Of Hemoplasma Infection In Domestic Cats From Valdivia, Southern Chile. Comp Immunol Microbiol Infect Dis. 46:20-6